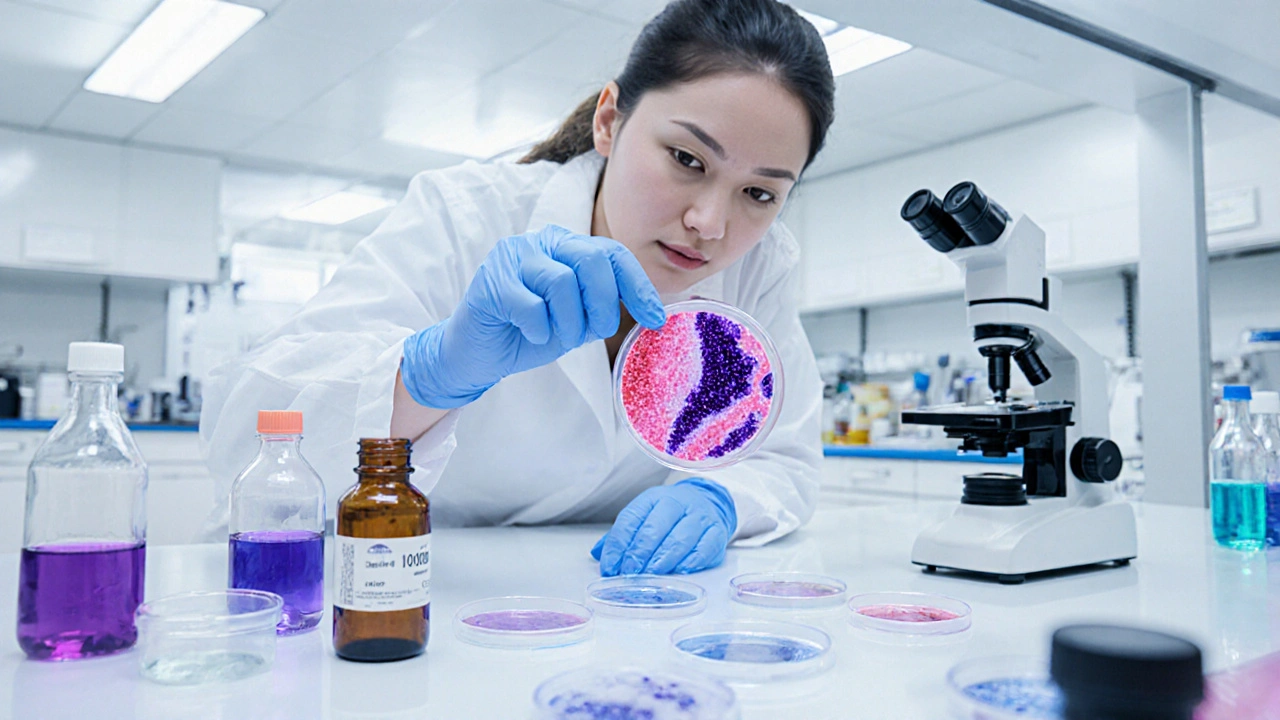
Bakteriologie v praxi: Laboratorní příběhy a diagnostika

HPV – co to je a proč na něj myslet
HPV (lidský papilomavirus) je běžný virus, který se přenáší hlavně pohlavním stykem. Většina lidí se s ním setká už během života, ale často si ani neuvědomí, že ho má. Některé typy HPV způsobují bradavice, jiné mohou vést k rakovině děložního čípku, anusu nebo hrdla.
Jak HPV ovlivňuje zdraví
Většina infekcí odezní sama, ale riskantní typy mohou zůstat skryté dlouho a postupně poškodit buňky. Pravidelné vyšetření a testy pomáhají virus zachytit včas. Pokud si všimnete neobvyklých změn, navštivte lékaře – včasná diagnostika šetří zdraví.
Očkování proti HPV – co potřebujete vědět
Očkování je nejúčinnější způsob, jak se chránit. Vakcína pokrývá nejnebezpečnější typy a je doporučena pro chlapce i dívky od 9 let. Dvakrát nebo třikrát podaná série vytváří silnou imunitu. Očkování není bolestivé a po vpichu můžete běžně pokračovat v běžných aktivitách.
Nečekejte, až se něco stane. Informujte se u svého lékaře, naplánujte očkování a sdílejte vědomosti s rodinou. Prevence je jednodušší, než léčba.

Jak se dostane E. coli do pochvy a co s tím dělat?
E. coli se do pochvy dostává hlavně z oblasti analního otvoru. Zjistěte, jak se přenáší, jaké jsou příznaky a jak se jí vyhnout bez zbytečného strachu.

Co se očkuje ve třech měsících? Plán očkování dětí v ČR
Ve třech měsících dítě dostává tři klíčové vakcíny proti šesti těžkým onemocněním. Zjistěte, co se očkuje, proč je to bezpečné a co dělat po očkování.

Přeočkování tetanu: Jak často a proč?
Zjistěte, jak často je potřeba přeočkovat tetanus, jaké jsou intervaly, typy vakcín a kdy je nutné odbočit od běžného desetiletého rozvrhu.

Jak poznat, že mám Helicobacter pylori? Praktický průvodce příznaky, testy a léčbou
Zjistěte, jak rozpoznat infekci Helicobacter pylori, jaké jsou příznaky, nejspolehlivější testy a moderní léčba v jednoduchém průvodci.

Virologie v boji proti globálním pandemiím - klíčové metody a úspěchy
Zjistěte, jak virologie odhaluje viry, urychluje vývoj vakcín a pomáhá bojovat s globálními pandemií pomocí moderních metod a praktických tipů.

Co se očkuje v 13 letech? Kompletní přehled vakcín
Kompletní přehled vakcín pro 13‑leté: co je povinné, co doporučené, jak probíhá očkování a co očekávat.

Bakteriologické vyšetření moči - jak dlouho trvá a co očekávat
Zjistěte, jak dlouho trvá bakteriologické vyšetření moči, co ovlivňuje dobu analýzy a jaké jsou moderní rychlé metody. Praktické tipy pro čekání na výsledek.

Jak se objednat na 4. dávku očkování - krok za krokem
Kompletní návod, jak se objednat na čtvrtou dávku očkování v ČR - krok za krokem, tipy, požadované dokumenty a FAQ.
Bakteriologie v praxi: Laboratorní příběhy a diagnostika
Praktický průvodce bakteriologií: od Gramova barvení po PCR, antibiotogram a reálné laboratorní příběhy, které ukazují, jak rychle a přesně diagnostikovat infekce.

Co je hexavakcína? Kompletní přehled kombinované vakcíny
Hexavakcína je kombinovaná vakcína chránící před šesti nemocemi. Zjistěte, jak funguje, jaký je očkovací plán a jaké má výhody i rizika.